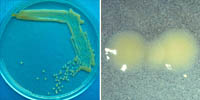

Updated 2007.
: Mancha bacteriana de pimentão e tomate
: Xanthomonas euvesicatoria and Xanthomonas perforans = [Xanthomonas axonopodis (syn. campestris) pv. vesicatoria], Xanthomonas vesicatoria, and Xanthomonas gardneri
: Pimentão (Capsicum spp.) e tomateiro (Solanum lycopersicum) (hospedeiros de importância econômica)

Desfolhamento e diminuição de rendimento de frutos por mancha bacteriana (ao fundo).
Sintomas e signos
A mancha bacteriana ocorre em pimentão e tomate. Muitas das características da doença são similares nas duas culturas. O foco da informação apresentada aqui é no pimentão. No mundo, 36 milhões de toneladas de pimentões são produzidos para consumo in natura e para uso como tempero. Nos Estados Unidos, os frutos em forma de sino são os mais familiares (Figura 1); no entanto, pimentões de outras formas (Figura 2) são amplamente cultivados.

Figura 1 |

Figura 2 |

Figura 3 |

Figura 4 |

Figura 5 |

Figura 6 |
A bactéria ataca folhas, caules e frutos de pimentões e tomateiros. No pimentão, as lesões podem formar-se nos frutos, incluindo o pedúnculo (Figura 3), mas a maior parte das perdas (Figura 4) resulta da queda de flores e de frutos jovens em desenvolvimento. Os frutos que permanecem, geralmente não são comercializados por causa da baixa qualidade. Estes podem apresentar lesões e estão frequentemente deformados e danificados devido à excessiva exposição ao sol como resultado do desfolhamento da planta. Isto pode resultar na escaldadura do fruto pelo sol (Figura 5). As folhas doentes caem prematuramente, resultando em desfolhamento extensivo. À medida que as folhas recém emergidas são infetadas e o desfolhamento das mais velhas continua, a planta fica com folhas somente na parte superior dos ramos (Figura 6). Geralmente, o desfolhamento é mais comum em pimentões do que em tomateiros. Por causa da folhagem doente que frequentemente permanece nos tomateiros, as plantas afetadas podem apresentar uma aparência chamuscada (Figura 7).

Figura 7 |

Figura 8 |

Figura 9 |
Folhas
Desde que os sintomas mais óbvios ocorrem nas folhas, a doença é frequentemente chamada de “mancha bacteriana da folha”. Os sintomas começam como lesões pequenas, verde-amareladas nas folhas jovens, as quais usualmente apresentam-se deformadas e curvadas (Figura 2), ou como lesões escuras, encharcadas e de aparência oleosa na folhagem mais velha (Figura 9).
As lesões crescem rapidamente até um tamanho de 0,25 a 0,5 cm de largura e se tornam bronzeadas a marrom-avermelhadas (castanho-avermelhadas, pt). A forma da lesão é definida pelos vasos condutores da folha, determinando uma forma angular, diferente da forma arredondada típica das manchas foliares causadas por fungos ou das injúrias causadas por alguns pesticidas e outros agroquímicos.
As lesões são frequentemente mais numerosas na ponta ou nas margens da folha onde a umidade é retida (como, por exemplo, o orvalho) (Figura 10). Sob condições de baixa umidade, as folhas doentes desenvolvem um aspecto esfarrapado, pois as margens foliares e o centro das lesões tornam-se necróticos, secam e desintegram-se. O tamanho da lesão é maior e os sintomas são mais severos quando ocorrem longos períodos (>12 horas) com 100% de umidade relativa.
Lesions often are more numerous at the tip and margin of the leaf where moisture such as dew is retained (Figura 10). Under dry conditions, diseased leaves can develop a tattered appearance as the leaf margin and lesion centers become necrotic, dry up and disintegrate. Lesion size is often larger and symptoms are more severe when extended periods (> 12 hours) of moisture-saturated tissue occur.

Figura 10 |

Figura 3 |

Figura 11 |
Frutos
As manchas nos frutos de pimentão e tomate podem ir até 0,5 cm e começam como áreas encharcadas de cor verde pálido, tornando-se, eventualmente, elevadas, marrons (castanhas, pt) e ásperas (Figuras 3 e 11). Essas manchas podem servir de pontos de entrada para invasores fúngicos e bacterianos que causam podridões secundárias de frutos. O patógeno que causa a mancha bacteriana não causa podridão de frutos.
Biologia do patógeno
Características do patógeno
A mancha bacteriana é causada por várias espécies de bactérias gram-negativas do gênero Xanthomonas. Em cultura, essas bactérias produzem colônias mucoides amarelas (Figura 12). Massas de bactérias podem ser vistas exsudando de uma lesão quando se corta transversalmente uma lesão foliar, se coloca o tecido numa gota de água, se cobre com lamínula sobre a amostra e se examina com microscópio (~200X) (Figura 13).
Figura 12 |

Figura 13 |
Classificação do patógeno e hospedeiros
A mancha bacteriana foi observada por primeira vez em tomate na África do Sul em 1914. Por quase meio século, uma só espécie bacteriana, classificada como Xanthomonas vesicatoria e posteriormente como X. campestris pv. vesicatoria, foi considerada a causa da mancha bacteriana de pimentão e tomate. No início da década de 90, foi demonstrado que dois diferentes grupos genéticos (possivelmente duas espécies) existiam dentro das estirpes do pv. vesicatoria. Em 1995, Vauterin et al. reestruturaram a classificação do gênero Xanthomonas propondo o status de espécie para esses grupos: X. vesicatoria e X. axonopodis (= campestris) pv. vesicatoria. Mais recentemente, foi demonstrado que as bactérias que causam mancha bacteriana pertencem a quatro grupos distintos (previamente designados como A, B, C e D). Jones et al. (2004) propuseram que esses grupos deveriam ter status de espécie: X. euvesicatoria = X. campestris (=axonopodis) pv. vesicatoria (grupo A), X. vesicatoria = X. vesicatoria (grupo B), X. perforans = grupo C e X. gardneri = grupo D. As estirpes do grupo A e B são as mais amplamente distribuídas. A grande maioria das estirpes que infetam pimentão pertencem ao grupo A e possivelmente existem algumas nos grupos B e D. Nenhuma estirpe de pimentão tem sido encontrada no grupo C; no entanto, estirpes dos quatro grupos tem sido isoladas de tomateiro. Algumas estirpes infetam somente pimentão (denominadas estirpes de pimentão), algumas somente infetam tomateiro (denominadas estirpes de tomate) e algumas podem infetar tanto pimentão quanto tomateiro (denominadas estirpes de pimentão/tomate). A gama de hospedeiros das diferentes estirpes pode ser determinada através da infiltração de uma suspensão bacteriana na folha e a observação da resposta. Das 18 até 36 horas, uma resposta resistente é indicada por um rápido colapso da área infiltrada (resposta de hipersensibilidade ou HR) (Figura 14). Numa planta suscetível, a área infiltrada desenvolve uma aparência clorótica e encharcada mas não antes de 3 a 5 dias após a infiltração.

Figura 14 |
Ciclo da doença e Epidemiologia

Disease Cycle |
A bactéria tem um período de sobrevivência muito limitado no solo que vai de dias a semanas. Por isso, sua sobrevivência quase sempre está associada a restos culturais de plantas doentes ou infetadas. Tem sido reportado que os patógenos persistem em associação com raízes de trigo e de umas poucas ervas daninhas. Essas ervas daninhas, no entanto, são consideradas pouco importantes na sobrevivência do patógeno. Plantas de tomate voluntárias são importantes fontes potenciais de inóculo em alguns locais. Em regiões mais frias onde o material vegetativo morre, a bactéria raramente sobrevive. Nessas áreas, a reintrodução ocorre primariamente a partir de semente contaminada ou mudas infectadas.

Figura 15 |

Figura 16 |
O patógeno pode sobreviver em associação com a semente, tanto externa quanto internamente. Na semente infestada externamente, os cotilédones podem tornar-se infetados por contato com o tegumento da semente e exibir lesões logo após a emergência do solo (Figura 15). As bactérias são rapidamente distribuídas por respingos a outras folhas e outras plantas. Especificamente, a doença é uma ameaça na produção de mudas (Figura 16). As bandejas de mudas favorecem o desenvolvimento da mancha bacteriana porque as plantas são irrigadas frequentemente e estão adensadas. Em 24 horas, as bactérias podem multiplicar-se rapidamente e produzir milhões de células. O risco de transmissão a partir da superfície da semente pode ser reduzido tratando a semente com hipoclorito de sódio ou de cálcio ou com fosfato trissódico. Atingir as bactérias que se encontram internamente é mais complicado. Tratamentos químicos ou térmicos que matam o patógeno na semente podem danificar e matar a semente também.
Apesar da mancha bacteriana ser uma doença de regiões cálidas e úmidas, pode desenvolver-se em regiões áridas sob irrigação. As bactérias podem disseminar-se pela chuva ou por irrigação por aspersão e também através das gotículas de água quando os agroquímicos são aplicados com pulverizadores de alta pressão.
As bactérias entram através dos estômatos (estomas, pt) na superfície das folhas e através de ferimentos nas folhas e frutos, como aqueles causados pela abrasão de partículas de areia causada pelo vento. Períodos prolongados de alta umidade relativa favorecem a infecção e o desenvolvimento da doença. O desenvolvimento dos sintomas é retardado e pode parar quando a umidade relativa permanece baixa por longos períodos de tempo após a infecção.
Manejo da (Meios de luta para a, pt) mancha bacteriana de pimentão e tomate
A estratégia básica de manejo da (meios de luta para a, pt) mancha bacteriana começa com o uso de semente certificada, livre do patógeno e mudas sadias. A rotação de culturas é recomendada, já que a bactéria não apresenta boa sobrevivência nos restos culturais. Uma vez que a bactéria é introduzida numa área ou na casa-de-vegetação, a doença é muito difícil de controlar.
Plantas de pimentão são rotineiramente pulverizadas com bactericidas à base de cobre para manter uma camada “protetora” nas folhas e nos frutos (Figura 17). Estirpes do patógeno resistente ao cobre e/ou ao antibiótico estreptomicina são bastante comuns e podem ser detectadas plaqueando as bactérias em meio contendo esses compostos (Figura 18). Os genes que codificam a resistência ao cobre e à estreptomicina podem estar nos plasmídeos (DNA extra-cromossómico) contidos nas células bacterianas. A presença destes genes nos plasmídeos permite a rápida propagação da resistência para outras bactérias não resistentes.

Figura 17 |

Figura 18 |

Figura 19 |
Embora cultivares resistentes estão disponíveis e são amplamente cultivados, há estirpes do patógeno capazes de quebrar todos os genes maiores de resistência conhecidos atualmente (Figura 19). No presente, três genes de segregação independente formam a base da resistência à mancha bacteriana nos cultivares comerciais de pimentão. Estirpes do patógeno que reagem diferentemente com os genes de resistência da planta de pimentão são denominados raças. Após o reporte de um quarto gene de resistência em 1998, 11 raças podem ser diferenciadas utilizando pimentões. A resistência não é tão fácil de ser encontrada e utilizada no tomate. Antigamente, reconheciam-se quatro raças que infetavam tomateiro. Com as mudanças taxonômicas propostas, estas têm assumido o status de espécies (Jones et al., 2004).
As opções de controle biológico da mancha bacteriana são limitadas. No entanto, um método de controle biológico que usa vírus bacterianos (bacteriófagos) que matam especificamente patógenos bacterianos está disponível atualmente. O tratamento com esse bacteriófago, comercializado como “AgriPhage”, tem sido bem sucedido na redução da doença, especialmente na produção de mudas em condições de casa-de-vegetação.
Importância
A mancha bacteriana é uma das doenças mais devastadoras de pimentão e tomate. A doença ocorre em todas as regiões úmidas e quentes do mundo onde estas culturas são cultivadas. Quando a doença ocorre logo após o transplanto e as condições do tempo são favoráveis para o seu desenvolvimento, é frequente a perda total da cultura. Atualmente, o controle químico está limitado ao uso de pulverizações de compostos à base de cobre combinados com manebe, produtos que não são muito eficientes. Por isso, esta doença é muito difícil de controlar uma vez que a epidemia está em desenvolvimento. Quando a doença ocorre cedo em cultivos comercias de pimentão, alguns produtores destroem a cultura por causa do elevado custo e dificuldade de controle.
O estudo deste patógeno bacteriano tem melhorado significativamente o conhecimento das interações patógeno-hospedeiro e o modelo gene-a-gene ao nível molecular. Este modelo estabelece que para cada gene de resistência no hospedeiro existe um gene de avirulência correspondente no patógeno. Um gene de avirulência (também chamado de gene efetor) codifica um produto que interage direta, ou mais provavelmente de forma indireta, com um produto codificado pelo gene de resistência correspondente na planta e esta interação provoca a resistência. Em plantas que não apresentam o correspondente gene de resistência, o produto do gene efetor suprime as defesas inatas do hospedeiro. Nos pimentões que carregam um desses genes de resistência, a resistência é expressa como resposta de hipersensibilidade (Figura 14). Um gene de avirulência bacteriano pode ser perdido ou sofrer mutação. Essa mudança genética no patógeno permite mudanças nas raças que quebram a resistência do hospedeiro, e consequentemente, a gama de hospedeiros do patógeno é ampliada. Os genes de avirulência conhecidos nos patógenos que causam mancha bacteriana de pimentão e tomate têm sido clonados e a sequência de DNA determinada para a maioria deles. Seu estudo tem melhorado o conhecimento da gama de hospedeiros e a resistência genética. O genoma completo de uma estirpe deste patógeno foi sequenciado recentemente ajudando a entender melhor os mecanismos que permitem ao microrganismo comportar-se como patógeno de plantas.

Figura 14 |
Referências selecionadas
Balogh, B., J.B. Jones, M.T. Momol, S.M. Olson, A. Obradovic, P. King, and L.E. Jackson. 2003. Improved efficacy of newly formulated bacteriophages for management of bacterial spot on tomato. Plant Disease 87: 949-954.
Bouzar, H., J.B. Jones, R.E. Stall, F.J. Louws, M. Schneider, J.L.W. Rademaker, F.J. de Bruijn, and L.E. Jackson. 1999. Multiphasic analysis of xanthomonads causing bacterial spot disease on tomato and pepper in the Caribbean and Central America: Evidence for common lineages within and between countries. Phytopathology 89:328-335.
DeWitt, D. and N. Gerlach. 1990. The Whole Chile Pepper Book. Little, Brown and Co., Boston.
Jones, J.B. 1991. Bacterial spot. Page 27 in: Compendium of Tomato Diseases. J.B. Jones, J.P. Jones, R.E. Stall, and T.A. Zitter, eds. American Phytopathological Society, St. Paul, MN.
Jones, J.B., R.E. Stall, and H. Bouzar. 1998. Diversity among xanthomonads pathogenic on pepper and tomato. Annual Review of Phytopathology 36:41-58.
Jones, J.B., G.H. Lacy, H. Bouzar, R.E. Stall, and N.W. Schaad. 2004. Reclassification of the xanthomonads associated with bacterial spot disease of tomato and pepper. Systematic and Applied Microbiology 27: 755-762.
Kousik, C.S. and D.F. Ritchie. 1996. Race shift in Xanthomonas campestris pv. vesicatoria within a season in field-grown pepper. Phytopathology 86:952-958.
Minsavage, G.V., D. Dahlbeck, M. Whalen, B. Kearney, U. Bonas, B.J. Staskawicz, and R.E. Stall. 1990. Gene-for-gene relationship specifying disease resistance in Xanthomonas campestris pv. vesicatoria-pepper interactions. Molecular Plant-Microbe Interactions 3:41-47.
Jones, J.B. and K. Pernezny. 2003. Bacterial spot. Pages 6-7 in: Compendium of Pepper Diseases. K. Pernezny, P.D. Roberts, J.F. Murphy, and N.P. Goldberg, eds. American Phytopathological Society, St. Paul, MN.
Sahin, F. and S.A. Miller. 1996. Characterization of Ohio strains of Xanthomonas campestris pv. vesicatoria, causal agent of bacterial spot of pepper. Plant Disease 80:773-778.
Swords, K.M.M., D. Dahlbeck, B. Kearney, M. Roy, and B.J. Staskawicz. 1996. Spontaneous and induced mutations in a single open reading frame to both virulence and avirulence in Xanthomonas campestris pv. vesicatoria avrBs2. Journal of Bacteriology 178:4661-4
669.
Vauterin, L., B. Hoste, K. Kersters, and J. Swings. 1995. Reclassification of Xanthomonas. International Journal of Systematic Bacteriology 45:472-489.
